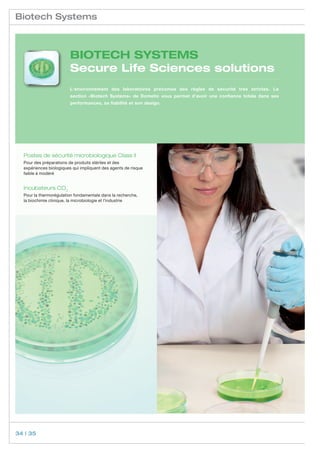
Biotech Systems



                         BIOTECH SYSTEMS
                         Secure Life Sciences solutions
                         L‘environnement des laboratoires préconise des règles de sécurité très strictes. La
                         section «Biotech Systems» de Dometic vous permet d‘avoir une confiance totale dans ses
                         performances, sa fiabilité et son design.




  Postes de sécurité microbiologique Class II
  Pour des préparations de produits stériles et des
  expériences biologiques qui impliquent des agents de risque
  faible à modéré


  Incubateurs CO2
  Pour la thermorégulation fondamentale dans la recherche,	
  la biochimie clinique, la microbiologie et l’industrie




34 | 35

Dometic Medical Systems se spécialise dans le développement et la distribution d'équipements de réfrigération pour les laboratoires et les secteurs médicaux, visant à garantir la sécurité des produits sensibles à la température. La société propose des normes de sécurité 'silver' et 'gold', ainsi qu'une gamme de produits respectant des directives environnementales strictes. Dometic est reconnu pour sa coopération avec des organisations internationales et fournit des équipements conformes à la directive européenne 93/42/CEE.